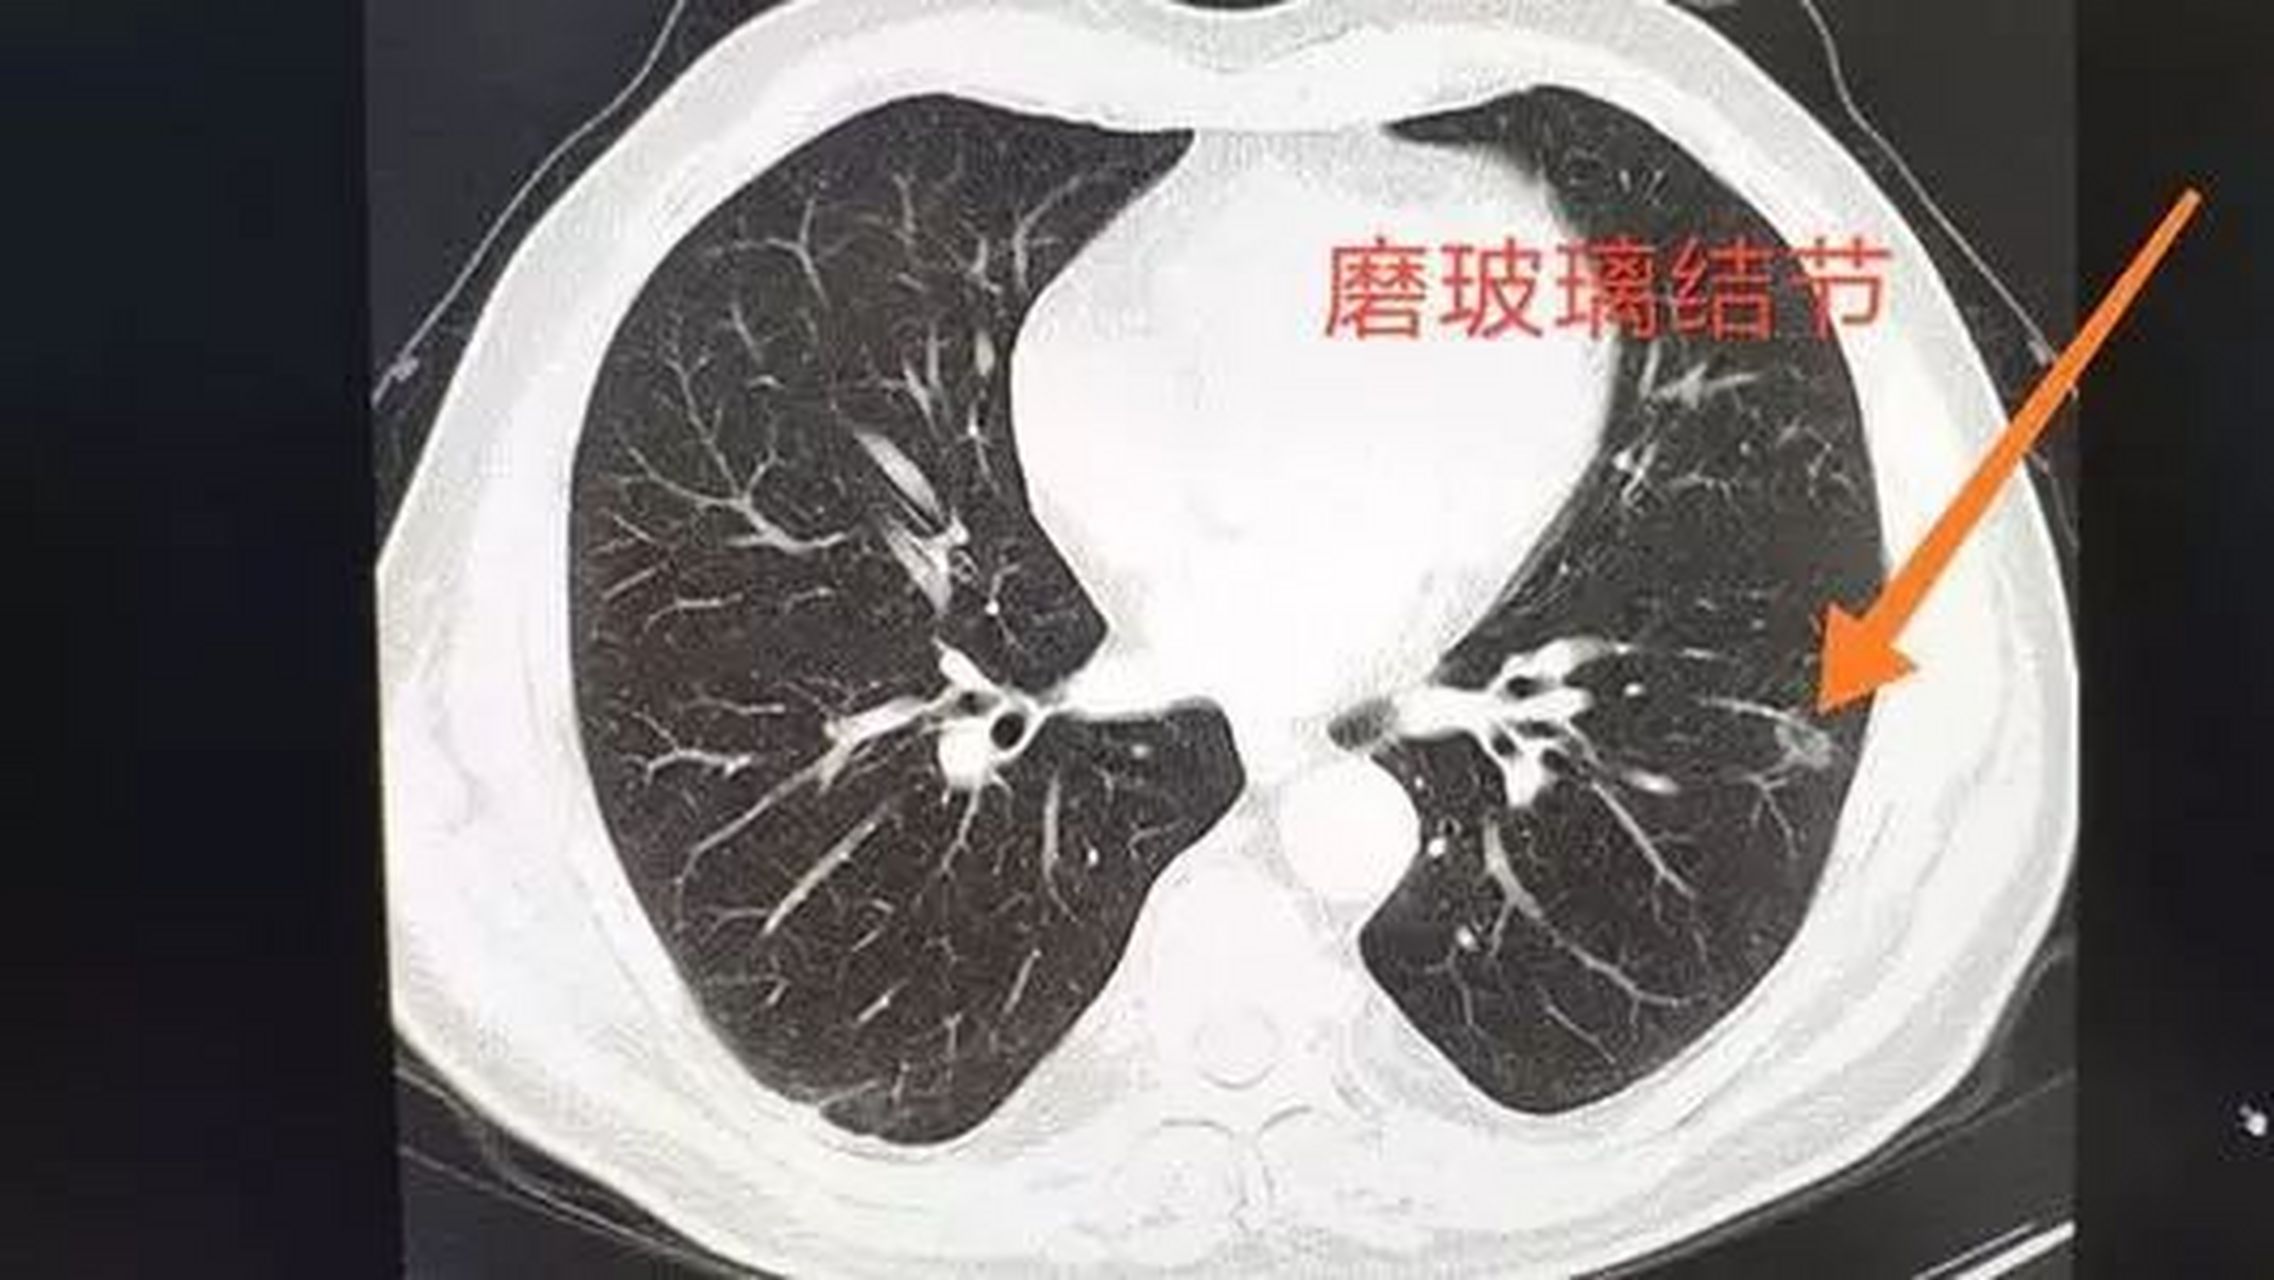
听郭医生详细说,不要再被谎言误导了,很多肺结节患者,都深受其害.

肺部实性结节

上两图示左肺上叶密度偏高的实性结节,边缘略显模糊
图片尺寸512x512
肺结节读片(21):鉴别11mm的实性结节良恶性的技巧 - 好大夫在线
图片尺寸1080x918
检查发现肺实性结节怎么办个人版实用指南
图片尺寸512x512
发现肺结节怎么办,读完这篇文章,你就不慌了
图片尺寸1080x1096
肺磨玻璃结节消融后形成的实性结节,它的边边上又长出磨玻璃结节怎么
图片尺寸1138x1600
形态很典型的10mm实性结节,确诊却花了一个月!
图片尺寸471x344
检查发现肺实性结节怎么办个人版实用指南
图片尺寸950x951
核保实例磨玻璃肺结节6mm重疾险除外承保
图片尺寸1080x547
肺部5mm微小实性结节,有可能是恶性程度最高的肺癌_肺癌_症状表现
图片尺寸866x679
肺结节是肺部受损的一种表现,一般来说,肺结节较小的话,很难被察觉,不
图片尺寸640x436
检查发现肺实性结节怎么办个人版实用指南
图片尺寸512x512
问诊分析:这样的右上肺实性结节像不像恶性? - 好大夫在线
图片尺寸916x838
实性肺结节的良恶性ct征象解析
图片尺寸1080x608
肺部实性结节不能小觑尤其是这类患者
图片尺寸306x446
听郭医生详细说,不要再被谎言误导了,很多肺结节患者,都深受其害.
图片尺寸2274x1280
肺结节的真实世界7
图片尺寸3024x4032
肺部结节_介绍_就诊指导 - 好大夫在线
图片尺寸499x310
肺部结节_介绍_就诊指导 - 好大夫在线
图片尺寸2748x3664
这样的肺实性结节,即便pet-ct示未见代谢增高,仍极力建议切除!
图片尺寸1386x923
肺结节的真实世界4 - 好大夫在线
图片尺寸3024x4032